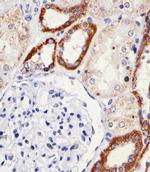
SNX3 Antibody in Immunohistochemistry (Paraffin) (IHC (P))
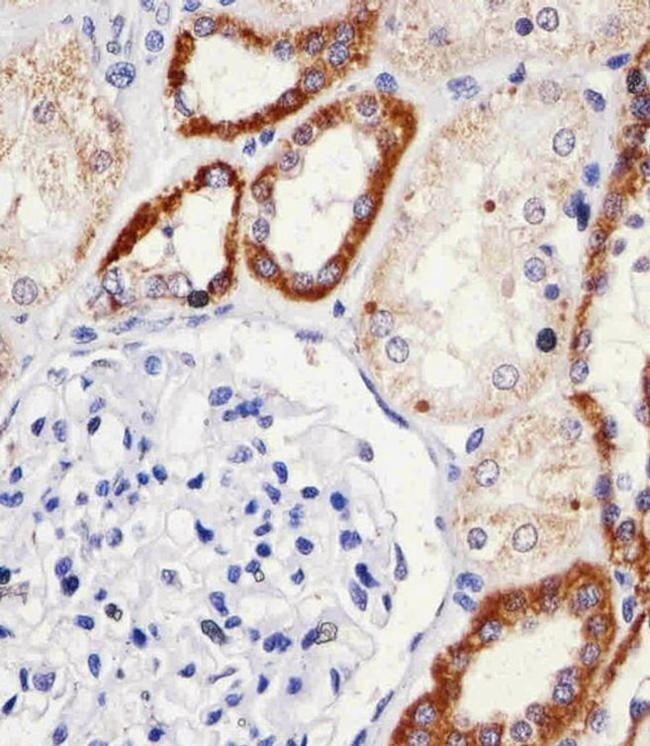
SNX3 Antibody in Immunohistochemistry (Paraffin) (IHC (P))

Search
Invitrogen
SNX3 Polyclonal Antibody
{{$productOrderCtrl.translations['antibody.pdp.commerceCard.promotion.promotions']}}
{{$productOrderCtrl.translations['antibody.pdp.commerceCard.promotion.viewpromo']}}
{{$productOrderCtrl.translations['antibody.pdp.commerceCard.promotion.promocode']}}: {{promo.promoCode}} {{promo.promoTitle}} {{promo.promoDescription}}. {{$productOrderCtrl.translations['antibody.pdp.commerceCard.promotion.learnmore']}}
图: 1 / 4
SNX3 Antibody (PA5-49025) in IHC (P)

产品信息
PA5-49025
宿主/亚型
分类
类型
抗原
偶联物
形式
浓度
保存条件
运输条件
RRID
产品详细信息
Predicted to react with bovine and rat based on sequence homology.
靶标信息
This gene encodes a member of the sorting nexin family. Members of this family contain a phox (PX) domain, which is a phosphoinositide binding domain, and are involved in intracellular trafficking. This protein does not contain a coiled coil region, like most family members. This protein interacts with phosphatidylinositol-3-phosphate, and is involved in protein trafficking. A pseudogene of this gene is present on the sex chromosomes. Alternative splicing results in multiple transcript variants encoding distinct isoforms.
仅用于科研。不用于诊断过程。未经明确授权不得转售。